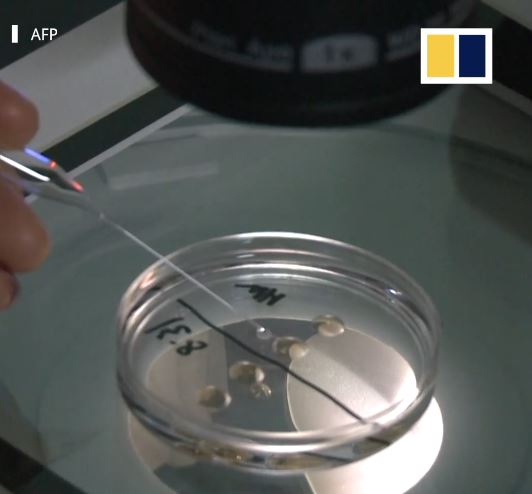

Pria Mengkloning Kucingnya yang Telah Mati karena Terlalu Sayang, Kini Senang Bisa Bersama Lagi
Pria Mengkloning Kucingnya yang Telah Mati karena Terlalu Sayang, Kini Senang Bisa Bersama Lagi
Namun di China, ada hukum khusus yang mengatur tentang kloning hewan.
Perusahan kloning pertama di China, Sinogene, telah beberapa kali berhasil melakukan kloning anjing.
Perusahaan itu berbasis di Beijing.
Baca: VIRAL! Dibilang Boleh Pakai Apa Saja di Pernikahan Kakaknya, Wanita Ini Justru Kenakan Kostum T-Rex

Sinogene dibentuk pada tahun 2015 karena ada banyaknya permintaan pasar.
Menurut hasil survei yang dilakukan Sinogene, ada sekitar 1000 orang yang menginginkan layanan ini.
Beberapa untuk peliharaan, namun ada pula yang dipergunakan untuk penelitian medis.
Masyarakat, khususnya pecinta hewan, ingin sekali hewan peliharaannya hidup kembali dengan cara kloning.
Hingga kini, Sinogene telah melakukan lebih dari 40 kloning anjing.
Baca: Viral, ABG Berkelahi di Sebuah Kafe di Purwokerto, Saling Siram Air Es dan Tarik Rambut

Untuk biaya, dibutuhkan sekitar 380.000 Yuan (Rp751 juta) untuk satu ekor anjing.
Sedangkan untuk kucing yang dibawa Huang Yu ke Sinogene, ia menghabiskan sekitar Rp480 juta.
Baca: Disebut Elza Syarief Informan Polisi & Kebal Hukum, Nikita Mirzani: Jangan Fitnah, Itu Gak Baik Bu

Untuk melakukan kloning kucing tersebut, sel diambil dari tubuh kucing yang telah meninggal.
Kemudian sel itu akan diinjeksikan ke dalam embrio yang dikandung oleh induk kucing pengganti.

![[FULL] Kesaksian Murid yang Belajar di Markas PKI sebelum G30S, Ungkap Kondisi Sumur Lubang Buaya](https://img.youtube.com/vi/Y9-ffUbZuwc/mqdefault.jpg)





